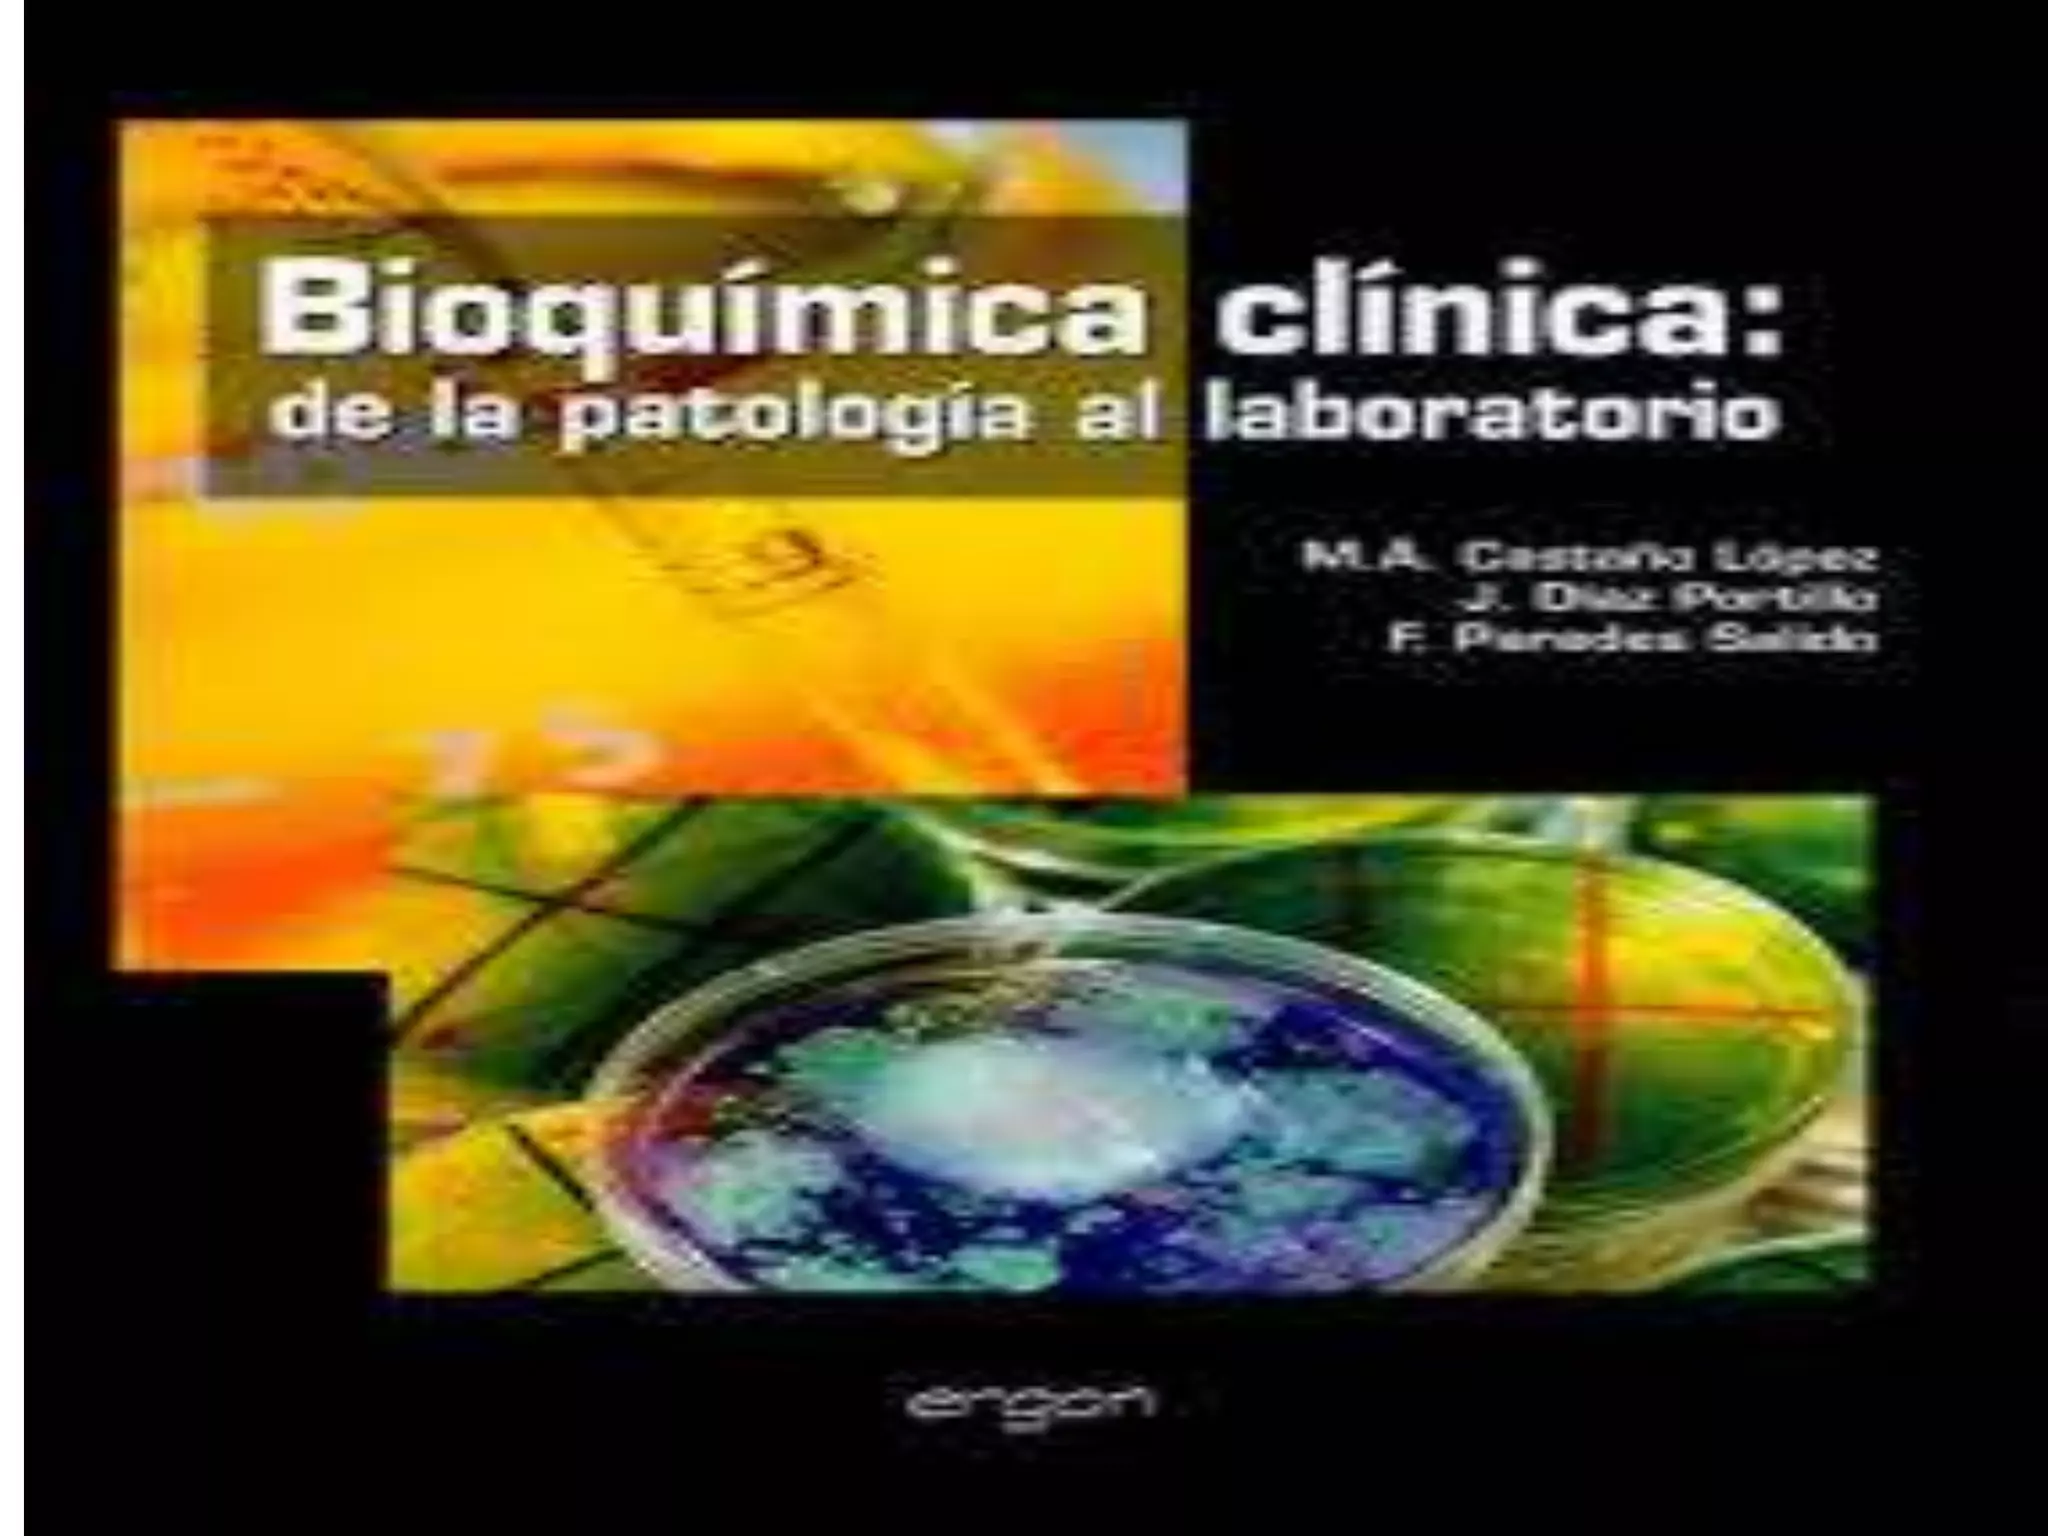

Incrustar presentación
Descargar para leer sin conexión



La bioquímica clínica estudia las propiedades bioquímicas in vitro e in vivo con el fin de proveer información para la prevención, diagnóstico, pronóstico y tratamiento de enfermedades. El bioquímico clínico es responsable de tomar muestras biológicas, analizarlas y validar los resultados para su interpretación médica. Los requisitos para la especialidad varían entre países, requiriendo algunos una licenciatura en medicina mientras que otros permiten a bioquímicos, farmacéuticos, biólog